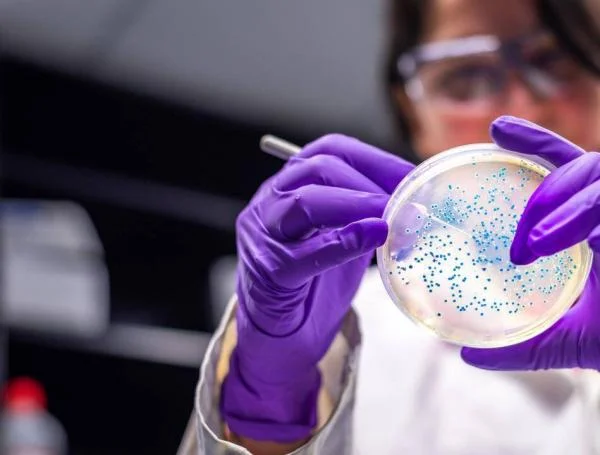
Zosurabalpín

-
 ...demuestra que microorganismos causan enfermedades (base para vacunas). (Glick Pasternak, 2010).
...demuestra que microorganismos causan enfermedades (base para vacunas). (Glick Pasternak, 2010). -
 ...cuando el bacteriólogo Alexander Fleming observó accidentalmente que un hongo del género Penicillium inhibía el crecimiento de bacterias en una de sus placas de cultivo. Este hallazgo marcó el inicio de la era de los antibióticos, revolucionando el tratamiento de infecciones bacterianas y salvando millones de vidas. Aunque al principio fue difícil de producir, años después se logró su fabricación a gran escala. (Glick Pasternak, 2010).
...cuando el bacteriólogo Alexander Fleming observó accidentalmente que un hongo del género Penicillium inhibía el crecimiento de bacterias en una de sus placas de cultivo. Este hallazgo marcó el inicio de la era de los antibióticos, revolucionando el tratamiento de infecciones bacterianas y salvando millones de vidas. Aunque al principio fue difícil de producir, años después se logró su fabricación a gran escala. (Glick Pasternak, 2010). -
...(fermentación aerobia), salvando vidas en la Segunda Guerra Mundial. Este avance impulsó el desarrollo masivo de antibióticos y sentó las bases de la biotecnología médica. (González, 2011).
-
 ...describen la estructura del ADN como una doble hélice, compuesta por dos cadenas entrelazadas de nucleótidos. Esta forma helicoidal explicó cómo el ADN almacena y transmite la información genética, y permitió entender los mecanismos de replicación y herencia. Su descubrimiento fue un hito fundamental en la biología molecular. (González, 2011).
...describen la estructura del ADN como una doble hélice, compuesta por dos cadenas entrelazadas de nucleótidos. Esta forma helicoidal explicó cómo el ADN almacena y transmite la información genética, y permitió entender los mecanismos de replicación y herencia. Su descubrimiento fue un hito fundamental en la biología molecular. (González, 2011). -
 ...Stanley Cohen, Paul Berg y Herbert Boyer realizaron los primeros experimentos de ingeniería genética al introducir ADN recombinante en bacterias. Usaron enzimas de restricción para cortar y unir fragmentos de ADN, lo que permitió insertar genes de un organismo en otro. Este avance marcó el inicio de la biotecnología moderna y abrió el camino para la manipulación genética con fines médicos e industriales. (González, 2011).
...Stanley Cohen, Paul Berg y Herbert Boyer realizaron los primeros experimentos de ingeniería genética al introducir ADN recombinante en bacterias. Usaron enzimas de restricción para cortar y unir fragmentos de ADN, lo que permitió insertar genes de un organismo en otro. Este avance marcó el inicio de la biotecnología moderna y abrió el camino para la manipulación genética con fines médicos e industriales. (González, 2011). -
 ...Georges Köhler y César Milstein desarrollaron una técnica revolucionaria para producir anticuerpos monoclonales, utilizando células híbridas llamadas hibridomas. Estos anticuerpos son idénticos y específicos contra un solo antígeno, lo que permitió su uso en el diagnóstico y tratamiento de diversas enfermedades, incluyendo ciertos tipos de cáncer. Su descubrimiento marcó un hito en la medicina y la biotecnología. (Glick Pasternak, 2010).
...Georges Köhler y César Milstein desarrollaron una técnica revolucionaria para producir anticuerpos monoclonales, utilizando células híbridas llamadas hibridomas. Estos anticuerpos son idénticos y específicos contra un solo antígeno, lo que permitió su uso en el diagnóstico y tratamiento de diversas enfermedades, incluyendo ciertos tipos de cáncer. Su descubrimiento marcó un hito en la medicina y la biotecnología. (Glick Pasternak, 2010). -
 ...la empresa Genentech logró un avance histórico al producir insulina humana recombinante utilizando la bacteria Escherichia coli. Mediante técnicas de ingeniería genética, insertaron el gen humano de la insulina en el ADN de la bacteria, permitiéndole sintetizar la hormona de forma segura y eficaz. Este desarrollo revolucionó el tratamiento de la diabetes y marcó el inicio de la biotecnología farmacéutica moderna. (Glick Pasternak, 2010).
...la empresa Genentech logró un avance histórico al producir insulina humana recombinante utilizando la bacteria Escherichia coli. Mediante técnicas de ingeniería genética, insertaron el gen humano de la insulina en el ADN de la bacteria, permitiéndole sintetizar la hormona de forma segura y eficaz. Este desarrollo revolucionó el tratamiento de la diabetes y marcó el inicio de la biotecnología farmacéutica moderna. (Glick Pasternak, 2010). -
...(primera insulina recombinante). (Glick Pasternak, 2010).
-
 ...La reacción en cadena de la polimerasa (PCR) fue inventada por Kary Mullis. Esta técnica revolucionaria permite amplificar segmentos específicos de ADN de manera rápida y precisa, facilitando su análisis en investigaciones genéticas, diagnóstico de enfermedades, medicina forense y biotecnología. Por este invento, Mullis recibió el Premio Nobel de Química en 1993.
...La reacción en cadena de la polimerasa (PCR) fue inventada por Kary Mullis. Esta técnica revolucionaria permite amplificar segmentos específicos de ADN de manera rápida y precisa, facilitando su análisis en investigaciones genéticas, diagnóstico de enfermedades, medicina forense y biotecnología. Por este invento, Mullis recibió el Premio Nobel de Química en 1993. -
 ...Fue un ambicioso proyecto de colaboración internacional con el objetivo de mapear y secuenciar la totalidad del ADN humano, es decir, identificar y comprender los más de 3 mil millones de pares de bases que conforman el genoma humano. Concluyó oficialmente en 2003, marcando un hito en la historia de la ciencia.
...Fue un ambicioso proyecto de colaboración internacional con el objetivo de mapear y secuenciar la totalidad del ADN humano, es decir, identificar y comprender los más de 3 mil millones de pares de bases que conforman el genoma humano. Concluyó oficialmente en 2003, marcando un hito en la historia de la ciencia. -
 ...fue el primer mamífero clonado a partir de una célula adulta mediante una técnica llamada transferencia nuclear de células somáticas. Dolly fue un avance científico histórico, ya que demostró que era posible reprogramar una célula adulta para desarrollar un organismo completo, lo que abrió nuevas posibilidades en la biotecnología, la medicina y la ética.
...fue el primer mamífero clonado a partir de una célula adulta mediante una técnica llamada transferencia nuclear de células somáticas. Dolly fue un avance científico histórico, ya que demostró que era posible reprogramar una célula adulta para desarrollar un organismo completo, lo que abrió nuevas posibilidades en la biotecnología, la medicina y la ética. -
 ...Se lanza la primera vacuna contra el virus del papiloma humano (VPH), producida mediante técnicas recombinantes. Representa un avance crucial en la prevención del cáncer.. (Glick Pasternak, 2010).
...Se lanza la primera vacuna contra el virus del papiloma humano (VPH), producida mediante técnicas recombinantes. Representa un avance crucial en la prevención del cáncer.. (Glick Pasternak, 2010). -
 ...CRISPR/Cas9 es un sistema de defensa de las bacterias que les permite identificar y destruir ADN viral usando la proteína Cas9 y un ARN guía. En 2012, Jennifer Doudna y Emmanuelle Charpentier demostraron que esta herramienta podía aplicarse a la edición genética, permitiendo modificar el ADN de forma precisa y revolucionando la ingeniería genética.
...CRISPR/Cas9 es un sistema de defensa de las bacterias que les permite identificar y destruir ADN viral usando la proteína Cas9 y un ARN guía. En 2012, Jennifer Doudna y Emmanuelle Charpentier demostraron que esta herramienta podía aplicarse a la edición genética, permitiendo modificar el ADN de forma precisa y revolucionando la ingeniería genética. -
 ...Las vacunas de ARN mensajero (ARNm) desarrolladas por Pfizer/BioNTech y Moderna marcaron un hito en la lucha contra la COVID-19. Estas vacunas utilizan una tecnología innovadora que introduce instrucciones genéticas (ARNm) para que las células produzcan una proteína del virus, lo que activa la respuesta inmune del cuerpo. Fueron las primeras vacunas de este tipo aprobadas para uso humano y demostraron alta eficacia en tiempo récord.
...Las vacunas de ARN mensajero (ARNm) desarrolladas por Pfizer/BioNTech y Moderna marcaron un hito en la lucha contra la COVID-19. Estas vacunas utilizan una tecnología innovadora que introduce instrucciones genéticas (ARNm) para que las células produzcan una proteína del virus, lo que activa la respuesta inmune del cuerpo. Fueron las primeras vacunas de este tipo aprobadas para uso humano y demostraron alta eficacia en tiempo récord. -
 ...Se realizó el primer tratamiento con edición genética directamente en el cuerpo humano (in vivo) para tratar la amiloidosis hereditaria por transtiretina, una enfermedad genética rara. Utilizando la tecnología CRISPR-Cas9, los científicos lograron modificar el gen defectuoso en el hígado del paciente, reduciendo significativamente la producción de la proteína dañina. Este avance marcó un paso crucial hacia terapias genéticas más precisas y duraderas.
...Se realizó el primer tratamiento con edición genética directamente en el cuerpo humano (in vivo) para tratar la amiloidosis hereditaria por transtiretina, una enfermedad genética rara. Utilizando la tecnología CRISPR-Cas9, los científicos lograron modificar el gen defectuoso en el hígado del paciente, reduciendo significativamente la producción de la proteína dañina. Este avance marcó un paso crucial hacia terapias genéticas más precisas y duraderas. -
 ...Primer trasplante exitoso de riñón de cerdo a humano con edición genética. Se utilizó un riñón de cerdo editado con tecnología CRISPR-Cas9 para eliminar genes porcinos potencialmente dañinos y añadir genes humanos que mejoraran la compatibilidad . Este avance representa un hito en el campo de los xenotrasplantes, ofreciendo una posible solución a la escasez de órganos para trasplante.
...Primer trasplante exitoso de riñón de cerdo a humano con edición genética. Se utilizó un riñón de cerdo editado con tecnología CRISPR-Cas9 para eliminar genes porcinos potencialmente dañinos y añadir genes humanos que mejoraran la compatibilidad . Este avance representa un hito en el campo de los xenotrasplantes, ofreciendo una posible solución a la escasez de órganos para trasplante. -
 ...(predicción de interacciones biomoleculares para diseño de fármacos). AlphaFold 3 es capaz de predecir con alta precisión las estructuras conjuntas de complejos biomoleculares, incluyendo proteínas, ácidos nucleicos, pequeñas moléculas, iones y residuos modificados. (Abramson et al., 2024).
...(predicción de interacciones biomoleculares para diseño de fármacos). AlphaFold 3 es capaz de predecir con alta precisión las estructuras conjuntas de complejos biomoleculares, incluyendo proteínas, ácidos nucleicos, pequeñas moléculas, iones y residuos modificados. (Abramson et al., 2024). -
...nuevo antibiótico contra Acinetobacter bacteria gramnegativa oportunista que causa infecciones graves en hospitales, especialmente en unidades de cuidados intensivos. Es conocida por su resistencia a múltiples antibióticos, incluyendo los carbapenémicos. Es responsable de neumonías, infecciones del tracto urinario, heridas y sepsis. Ha sido priorizada por la OMS como una amenaza urgente que requiere nuevos tratamientos antimicrobianos. (Zampaloni et al., 2024).
...nuevo antibiótico contra Acinetobacter bacteria gramnegativa oportunista que causa infecciones graves en hospitales, especialmente en unidades de cuidados intensivos. Es conocida por su resistencia a múltiples antibióticos, incluyendo los carbapenémicos. Es responsable de neumonías, infecciones del tracto urinario, heridas y sepsis. Ha sido priorizada por la OMS como una amenaza urgente que requiere nuevos tratamientos antimicrobianos. (Zampaloni et al., 2024). -
 ...(ensayo clínico exitoso). Esta enfermedad metabólica rara es causada por mutaciones en los genes que codifican las subunidades α y β de la enzima propionil-CoA carboxilasa, lo que lleva a la acumulación de metabolitos tóxicos y episodios recurrentes de descompensación metabólica. (Koeberl et al., 2024).
...(ensayo clínico exitoso). Esta enfermedad metabólica rara es causada por mutaciones en los genes que codifican las subunidades α y β de la enzima propionil-CoA carboxilasa, lo que lleva a la acumulación de metabolitos tóxicos y episodios recurrentes de descompensación metabólica. (Koeberl et al., 2024). -
 ...preservando la hematopoyesis. Un estudio reciente combinó ingeniería genética y terapias dirigidas para eliminar células malignas hematológicas con un ADC contra CD45, protegiendo simultáneamente células madre hematopoyéticas modificadas genéticamente para resistir el tratamiento (Garaudé et al., 2024).
...preservando la hematopoyesis. Un estudio reciente combinó ingeniería genética y terapias dirigidas para eliminar células malignas hematológicas con un ADC contra CD45, protegiendo simultáneamente células madre hematopoyéticas modificadas genéticamente para resistir el tratamiento (Garaudé et al., 2024).
A list shows items. A timeline shows sequence.
Use Timetoast to make dates, milestones, and turning points easier to understand in a clear visual format. Timetoast is a timeline maker for work, school, research, and stories.
